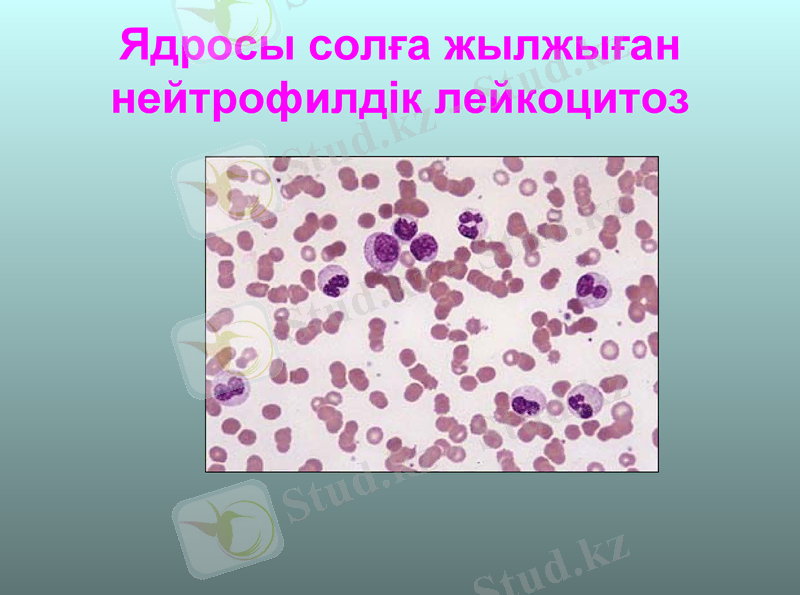
Slide 15
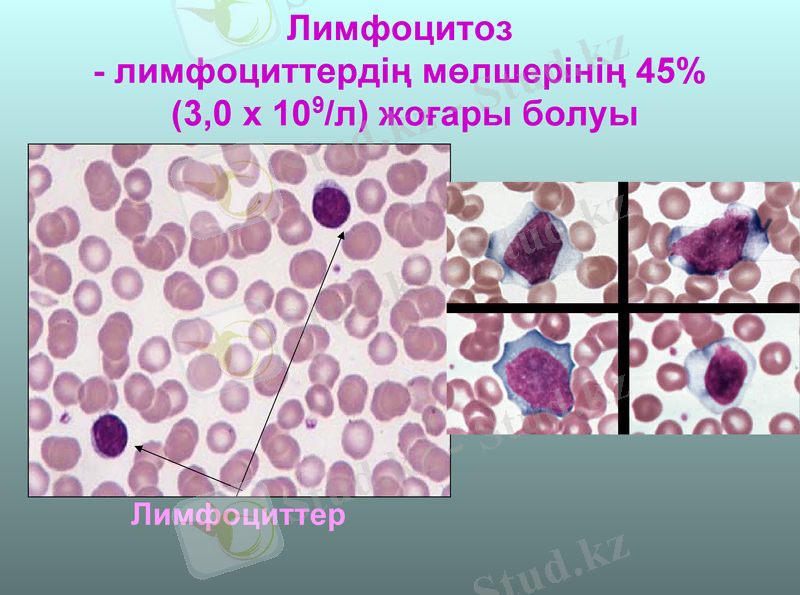
Slide 21

Лейкоцитоз бен лейкопения: жіктелуі, патогенезі және клиникалық маңызы



Лейкоцитоздар
Лейкоцитоздар - шеткі қанда лейкоциттердің саны көбеюі.
Қалыпты жағдайда лейкоциттердің саны
4 - 9 х 109/л

Лейкоцитоздардың жіктелуі
Организмдегі маңызы бойынша
Физиологиялық
Патологиялық
Патогенезі бойынша
Нағыз (лейкопоэздің белсенділенуі)
Қайта бөліністік (тамыр ішінде лейкоциттердің қайта бөлінісі)

Лейкоциттік өрнекте лейкоциттердің басымырақ ұлғаюы бойынша
Нейтрофилдік лейкоцитоз
Эозинофилдік лейкоцитоз
Базофилия
Лимфоцитоз
Моноцитоз

Физиологиялық лейкоцитоз
НАҒЫЗ
Жаңа туылғандардың
Жүкті әйелдердің
ҚАЙТА БӨЛІНІСТІК
Миогендік
Ауқаттық
Эмоциялық
Алғашқы екі апта
Жүктіліктің 5-6 айында және босанғаннан соң 2 -ші аптада
Ауыр қол жұмысын атқарғанда
Тамақ ішкеннен кейін 2-3 сағаттан соң
психикалық қозудың салдарынан

Патологиялық лейкоцитоз
Жұқпалық
Қабынулық
Уыттанулық
Постгеморрагиялық
Өспелерде

Бүліндірүші жайт
интерлейкин, (ИЛ-1, ИЛ - 6), ӨТЖЖ және басқа цитокиндердің түзілуі
Сүйек кемігінде тіректік жасушалар және Т-лимфоциттердің түрткіленуі
колония түрткілеуші жайттардың (КТЖ) түзілуі
лейкопоездің белсенділенуі
Сүйек кемігінен лейкоциттердің көп шығуы
Нағыз лейкоцитоздың патогенезі

Өсу күшейткіші және гранулоциттердің жетілуі
Өсу күшейткіші және гранулоциттердің, моноциттердің, макрофагтардың жетілуі
эозинофилдер түзілуінің күшейткіштері
лимфоциттердің өсіп өнуі және нақтылануының күшейткіштері
моноциттердің белсенділенуі
Колония түрткілеуші жайттар

Қайта бөліністік лейкоцитоздың патогенезі
Лейкоциттердің тамыр ішінде қайта бөлінісі (қабырғалық жиынтығынан қан ағымына түсуі)
Қордағы лейкоциттердің шеткері қанға шығарылуы

Нейтрофилдік лейкоцитоз нейтрофилдер мөлшерінің 65% (6, 0 х 109/л) жоғары болуы
Бөлшектенген ядролы нейтрофилдер

Іріңді қабыну кезінде
асептиқалық қабыну кезінде (миокард инфаркты, тромбофлебит, қан құйылуы, жабық сынықта)
регенераторлық анемияларда
аутоинтоксикацияларда (уремия, подагра)
жәндіктер шаққанда
өспелерде байқалады.

Нейтрофилдердің дегенерациялық түрлері
анизоцитоз (әр түрлі жасушалардың болуы)
пойкилоцитоз (нейтрофилдердің пішінінің өзгеруі)
ұытты түйіршіктенуі (цитоплазма нәруыздарының коагуляциясы)
цитоплазма және ядроның вакуолизациясы
гипохроматоз -ядроның боялу қабілетінің жоғалуы
фрагментация - ядроның кейбір бөлшектерінің бөлініп шығуы
пикноз -хроматиннің құрылымдарының қатаюы
кариорексис -ядроның бөліктерге ыдырауы
ядроның гиперсегментациясы

Нейтрофилдердің ядролық жылжуының түрлері
Нейтрофилдердің ядролық солға жылжуы - жас нейтрофилдердің көбейуі, лейкопоездің белсенділенуін мәлімдейді

Гемопоез

Сүйек кемігінде нейтрофилдердің жетілуі
Ядросы солға жылжыған нейтрофилдік лейкоцитоз

Гипорегенерациялық ядролық солға жылжу - таяқшаядролы нейтрофилдердің мөлшерінің көбейуі (5% жоғары)
Регенерациялық ядролық солға жылжу -таяқшаядролы нейтрофилдердің көбейуі және метамиелоциттердің пайда болуы
Гиперрегенерациялық ядролық солға жылжу -нейтрофилдердің жас түрлерінің- миелоциттердің, промиелоциттердің және тіпті миелобласттардың пайда болуы, анэозинофилиямен жиі қабаттасуы, іріңді-сепсистік аурулардың асқынуын көрсетеді

Нейтрофилдердің ядролық оңға жылжуы - көп бөлшектенген ядролы нейтрофилдердің лейкоциттердің дегенерациясы белгілерімен және таяқшаядролы нейтрофилдер санының азаюымен қабаттасып пайда болуы.

- Эозинофилді лейкоцитоз -
эозинофилдердің жалпы санының 5%-дан (0, 3 х 109/л) артық көбейуі
Қарапайымдар ауру туындатқанда (аскаридоз, описторхоз, лямблиоз ж. б. ), аллергиялық және аутоиммундық ауруларда (коллагеноздарда), глюкокортикоидтардың аз өндірілуінде, созылмалы миелолейкозда.

Эозинофилдік лейкоцитоз

Базофилдер(а), нейтрофилдер (b), эозинофилдер (с)
Базофилия
- қанда базофилдердің мөлшерінің артуы. Гемолиздік анемияларда, гемофилияда, егілу кезінде, бөгде нәруыздарды еңгізгенде, созылмалы миелолейкозда, созылмалы жаралы колит кезінде болуы мүмкін.
Лимфоцитоз - лимфоциттердің мөлшерінің 45% (3, 0 х 109/л) жоғары болуы
Лимфоциттер

Физиологиялық лимфоцитоз 10 жасқа дейінгі балаларда, вегетариандықтарда кездеседі.
Лимфоцитоз созылмалы бактериалық жұқпаларда қабаттасады (мерез, туберкулез, бруцеллез), жедел вирустық жұқпалар (көк жөтел), протозойлық жұқпалар (токсоплазмоз) . Созылмалы лимфолейкозға тән.

Моноцитоз
- Қанда моноциттердің мөлшері 9% (0, 6 х 109/л) жоғары болуы.
Моноцитоз иммундық үрдістерде байқалады, вирустық жұқпаларда кездеседі (шешек, қызылша, қызамық, инфекциялық паротит, жұқпалық мононуклеозда), күл ауруында, қарапайым жұқпаларда (лейшманиоз, малярия) .

Лейкоцитоздардың маңызы
Лейкоцитоз бүліндірүші жайттардың әсеріне организмнің қорғаныстық серпілісі болып табылады, организмнің арнайы және арнайы емес төзімділігінің жоғарылауын сипаттайды.

ЛЕЙКОПЕНИЯЛАР (лейкоцитопениялар)
Шеткі қанда лейкоциттердің саны 4, 0 х 109/л-ден азаюы

Жіктелуі
патогенезі бойынша
Лейкопоез тежелуімен және шеткі қанға лейкоциттердің шығуының баяулауымен сипатталатын лейкопениялар.
Қан тамырында лейкоциттердің артық ыдырауымен сипатталатын лейкопениялар.
Қан тамырында лейкоциттердің қайта бөлінуімен сипатталатын лейкопениялар.

Лейкоциттердің жеке түрлері бойынша
Нейтропениялар
Эозинопениялар
Лимфоцитопениялар
Моноцитопениялар
Лейкопениялар жиі нейтрофилдер санының азаюы - нейтропения нәтижесінде дамиды.

Нейтропениялардың себептері
Миелопоездің бағаналық жасушаларының иондаушы сәулемен, цитостатиктермен, вирустармен, антиденелермен зақымдануы.
Қан жасушаларының көбеюі мен жетілуіне қажетті заттардың (В12 витамині, фоль қышқылы, темір, пиридоксин, нәруыз) тапшылығы.
Гемопоез жасушаларының микроқоршауы зақымдануы және колония түрткілеуші жайттардың түзілуінің бұзылуы.
Миелопоез өсіндісінің өспе тінімен ауысуы.
Лейкоциттердің қимылдық белсенділігінің тұқым қуатын және жүре пайда болған төмендеуінен сүйек кемігінен шығуының бұзылуы.

Кейбір дәрі-дәрмектерді (амидопирин, сульфаниламидтер ж. б. ) қолданғанда, аутоиммунды ауруларда лейкоциттердің антиденелермен қарқынды ыдырауы.
Лейкоциттердің морфологиясы мен қызметінің толық жетілмегенінде артық ыдырауы (В12 витамині-тапшылықты анемия, Чедиак-Хигаси ауруы) .
- Іс жүргізу
- Автоматтандыру, Техника
- Алғашқы әскери дайындық
- Астрономия
- Ауыл шаруашылығы
- Банк ісі
- Бизнесті бағалау
- Биология
- Бухгалтерлік іс
- Валеология
- Ветеринария
- География
- Геология, Геофизика, Геодезия
- Дін
- Ет, сүт, шарап өнімдері
- Жалпы тарих
- Жер кадастрі, Жылжымайтын мүлік
- Журналистика
- Информатика
- Кеден ісі
- Маркетинг
- Математика, Геометрия
- Медицина
- Мемлекеттік басқару
- Менеджмент
- Мұнай, Газ
- Мұрағат ісі
- Мәдениеттану
- ОБЖ (Основы безопасности жизнедеятельности)
- Педагогика
- Полиграфия
- Психология
- Салық
- Саясаттану
- Сақтандыру
- Сертификаттау, стандарттау
- Социология, Демография
- Спорт
- Статистика
- Тілтану, Филология
- Тарихи тұлғалар
- Тау-кен ісі
- Транспорт
- Туризм
- Физика
- Философия
- Халықаралық қатынастар
- Химия
- Экология, Қоршаған ортаны қорғау
- Экономика
- Экономикалық география
- Электротехника
- Қазақстан тарихы
- Қаржы
- Құрылыс
- Құқық, Криминалистика
- Әдебиет
- Өнер, музыка
- Өнеркәсіп, Өндіріс
Қазақ тілінде жазылған рефераттар, курстық жұмыстар, дипломдық жұмыстар бойынша біздің қор #1 болып табылады.



Ақпарат
Қосымша
Email: info@stud.kz